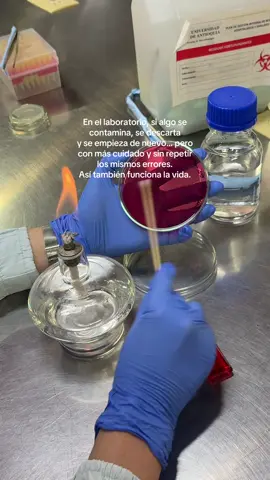

nisz | acne fighter 🌟
Region: ID
Monday 22 September 2025 12:39:22 GMT
357
11
0
0
Music
Download
Comments
There are no more comments for this video.
To see more videos from user @hfwdreams, please go to the Tikwm
homepage.